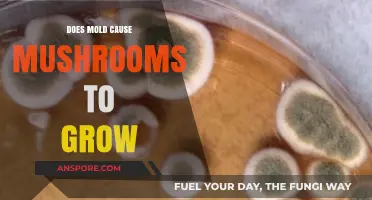
Mold and Mushrooms: Unraveling the Connection Between Fungi Growth

Chaga mushrooms, scientifically known as *Inonotus obliquus*, are a type of fungus that typically grows on birch trees in cold climates, such as those found in northern regions of North America, Europe, and Asia. While Georgia, located in the southeastern United States, is not traditionally associated with the cold environments where Chaga thrives, there is growing interest in whether this medicinal mushroom can be found or cultivated in the state. Georgia’s diverse ecosystems, including mountainous areas with cooler temperatures, raise questions about the potential for Chaga growth, either naturally or through controlled cultivation. Exploring this topic involves examining Georgia’s climate, tree species, and environmental conditions to determine if Chaga mushrooms can indeed grow in the region.
Explore related products
What You'll Learn

Chaga's preferred climate conditions
Chaga mushrooms (Inonotus obliquus) are a unique fungus that thrives in specific environmental conditions, primarily on birch trees in cold, northern climates. While Georgia, located in the southeastern United States, is not typically associated with the cold, boreal forests where Chaga is commonly found, understanding the mushroom's preferred climate conditions is essential to determine its potential growth in the region. Chaga mushrooms favor a continental climate with cold winters and mild summers, characterized by significant temperature fluctuations between seasons. These conditions are crucial for the fungus's life cycle, as the cold temperatures help weaken the birch trees, allowing Chaga to establish itself and grow.
In addition to temperature, Chaga mushrooms require a specific humidity level and precipitation pattern. They prefer a relative humidity of 60-80%, which is often present in the boreal forests of northern regions. Georgia's humidity levels can be high, especially during the summer months, but the overall climate lacks the consistent moisture and cool temperatures needed for Chaga growth. The state's annual precipitation, ranging from 100 to 150 cm (40 to 60 inches), is also not a limiting factor, but the distribution of rainfall throughout the year does not align with Chaga's preference for cool, moist conditions.
The type of forest ecosystem is another critical factor in Chaga's preferred climate conditions. Chaga mushrooms have a symbiotic relationship with birch trees, primarily Betula pendula and Betula pubescens, which are not native to Georgia. While birch trees can be found in some parts of the state, they are not as prevalent as in northern regions, and the overall forest composition is dominated by species like oak, pine, and hickory. This lack of suitable host trees further reduces the likelihood of Chaga mushrooms growing naturally in Georgia.
Despite these challenges, it is possible to cultivate Chaga mushrooms in controlled environments that mimic their preferred climate conditions. Indoor cultivation using birch logs and climate-controlled grow rooms can provide the necessary temperature, humidity, and host material for Chaga to grow. However, this approach requires significant resources and expertise, making it impractical for large-scale production in Georgia. In conclusion, while Georgia's climate does not naturally support the growth of Chaga mushrooms, understanding the fungus's preferred conditions highlights the importance of temperature, humidity, precipitation, and host tree availability in its life cycle.
Year-Round Morel Cultivation: Can Greenhouses Sustain Mushroom Growth?
You may want to see also

Georgia's forest types and habitats
Georgia, located in the southeastern United States, boasts a diverse range of forest types and habitats that support various ecosystems and species, including the potential for chaga mushrooms (*Inonotus obliquus*). These forests are influenced by the state's varied geography, climate, and soil conditions. Understanding Georgia's forest types is essential for determining whether chaga mushrooms, which typically grow on birch trees in colder climates, could thrive here.
One of the dominant forest types in Georgia is the mixed pine-hardwood forest, which covers much of the Piedmont and Coastal Plain regions. These forests are characterized by a mix of pine species, such as loblolly and shortleaf pine, alongside hardwoods like oak, hickory, and sweetgum. While birch trees, the primary host for chaga mushrooms, are not common in these areas, the diversity of tree species creates a rich habitat for other fungi and wildlife. The warmer climate in these regions may also limit the growth of chaga, as it typically prefers colder environments.
In the North Georgia mountains, the forest composition shifts to mixed oak-hickory and cove hardwood forests. These areas, part of the Appalachian Mountains, feature cooler temperatures and higher elevations, providing a more suitable environment for hardwood species like maple, beech, and birch. Birch trees, though not as abundant as in northern latitudes, can be found in scattered pockets, particularly in moist, shaded areas. This habitat is more conducive to chaga growth, as the cooler climate and presence of birch trees align with the fungus's preferred conditions.
Another important forest type in Georgia is the bottomland hardwood forest, found along river floodplains and wetlands. These forests are dominated by water-tolerant species such as cypress, tupelo, and oak. While birch trees are not typically present in these habitats, the unique ecological conditions support a wide variety of fungi and plant life. However, the warm, humid climate of these areas is less ideal for chaga mushrooms, which thrive in colder, drier environments.
Lastly, Georgia's longleaf pine ecosystems in the Coastal Plain are notable for their open, park-like structure and fire-adapted species. These forests historically covered vast areas but have been significantly reduced due to land-use changes. While longleaf pine forests do not support birch trees, they play a critical role in maintaining biodiversity and ecosystem health. The absence of birch trees in these habitats makes them unlikely locations for chaga growth.
In summary, while Georgia's diverse forest types and habitats provide a rich environment for various fungi, the presence of chaga mushrooms is limited by the scarcity of birch trees and the state's generally warmer climate. The North Georgia mountains, with their cooler temperatures and occasional birch trees, offer the most potential for chaga growth, though it remains relatively rare compared to northern regions. Understanding these forest types is key to exploring the possibilities of chaga cultivation or foraging in Georgia.
Exploring New Zealand's Forests: Do Magic Mushrooms Grow Here?
You may want to see also

Birch tree prevalence in Georgia
Birch trees (Betula spp.) are a critical factor in understanding the potential growth of chaga mushrooms (Inonotus obliquus) in Georgia, as chaga exclusively grows on birch trees. In Georgia, the prevalence of birch trees is relatively limited compared to regions like the northern United States, Canada, or Northern Europe, where chaga is commonly found. Birch trees are not native to Georgia and are not a dominant species in the state's forests. Georgia's native forests are primarily composed of pine, oak, hickory, and maple species, which do not support chaga growth. However, there are small pockets where birch trees have been introduced or planted, particularly in urban and suburban areas for ornamental purposes.
The climate of Georgia also plays a role in the scarcity of birch trees. Birch trees thrive in cooler, temperate climates with distinct seasons, whereas Georgia's climate is predominantly humid subtropical, characterized by hot summers and mild winters. These conditions are less favorable for birch trees, which prefer cooler temperatures and well-drained soils. While some birch species, such as the river birch (Betula nigra), are more tolerant of warmer climates and are occasionally found in Georgia, they are not widespread enough to support significant chaga growth.
For those interested in finding chaga in Georgia, the focus should be on areas where birch trees have been planted, such as parks, landscaping projects, or private properties. River birch, in particular, is more commonly seen in the state due to its adaptability to Georgia's soil and climate conditions. However, even in these limited locations, chaga growth is rare, as the fungus requires specific environmental conditions and a mature birch host, which are not frequently met in Georgia.
Efforts to cultivate birch trees in Georgia for chaga production would face challenges due to the state's climate and soil characteristics. Birch trees require acidic, well-drained soil and cooler temperatures, which are not typical across most of Georgia. Additionally, chaga takes many years to develop, and the fungus relies on the slow decay of birch wood, a process that is not easily replicated in non-native environments. Therefore, while birch trees can be found in Georgia, their limited prevalence and the state's climate make natural chaga growth highly unlikely.
In summary, the prevalence of birch trees in Georgia is minimal, primarily confined to ornamental plantings and occasional river birch specimens. This scarcity, combined with the state's unsuitable climate for birch trees, means that chaga mushrooms are not naturally found in Georgia. For those seeking chaga, it is more practical to look for sustainably harvested sources from regions where birch trees are abundant and chaga grows naturally, rather than attempting to find or cultivate it in Georgia.
Puffball Mushrooms in Ohio: Where and When to Find Them
You may want to see also
Explore related products

Chaga foraging regulations in Georgia
Chaga mushrooms (Inonotus obliquus) are indeed found in Georgia, particularly in the northern regions where the climate and forest ecosystems are conducive to their growth. These mushrooms typically grow on birch trees and are highly valued for their medicinal properties. However, foraging for Chaga in Georgia is not without regulations, and it’s essential for foragers to understand the legal and ethical guidelines to avoid penalties and protect the environment.
In Georgia, Chaga foraging is primarily regulated under the country’s forestry and environmental laws. The Georgian Forest Code and the Law on Environmental Protection outline the rules for harvesting non-timber forest products, including Chaga. According to these regulations, foraging for Chaga on public or state-owned lands typically requires a permit issued by the Ministry of Environmental Protection and Agriculture. This permit ensures that harvesting is done sustainably and does not harm the forest ecosystem. Unauthorized foraging on protected lands can result in fines or other legal consequences.
For private lands, the rules are less stringent, but permission from the landowner is still mandatory. Even on private property, foragers must adhere to sustainable practices, such as harvesting only mature Chaga and leaving enough behind to allow for regrowth. Overharvesting can damage the host birch trees and disrupt the forest’s biodiversity, so responsible foraging is crucial. Additionally, foragers should be aware of protected areas, such as national parks and nature reserves, where harvesting Chaga is strictly prohibited.
Exporting Chaga from Georgia is another area of regulation. The Georgian government monitors the export of non-timber forest products to prevent overexploitation and ensure compliance with international agreements, such as the Convention on International Trade in Endangered Species of Wild Fauna and Flora (CITES). While Chaga is not currently listed under CITES, exporters must still obtain the necessary documentation to prove that the harvested Chaga was collected legally and sustainably.
For those interested in foraging Chaga in Georgia, it’s advisable to consult local forestry offices or environmental agencies for up-to-date information on permits and regulations. Joining local mycological or foraging groups can also provide valuable insights into best practices and ethical harvesting techniques. By respecting these regulations, foragers can enjoy the benefits of Chaga while contributing to the conservation of Georgia’s rich forest ecosystems.
Lastly, ethical foraging practices extend beyond legal requirements. Foragers should prioritize the health of the forest and the longevity of Chaga populations. This includes avoiding harvesting from weakened or diseased trees, using clean tools to prevent contamination, and minimizing disturbance to the surrounding environment. By adopting a mindful and sustainable approach, foragers can ensure that Chaga remains a viable resource for future generations in Georgia.
Do Shiitake Mushrooms Thrive in Sunlight? Growing Tips Revealed
You may want to see also

Reported Chaga sightings in Georgia
Chaga mushrooms (Inonotus obliquus) are primarily associated with birch trees in cold, northern climates, such as those found in Siberia, Canada, and the northern United States. However, there have been reported sightings and discussions about Chaga in Georgia, both the country and the U.S. state. In the context of Georgia, USA, Chaga sightings are less common due to the region's warmer climate, but they are not entirely unheard of. Enthusiasts and foragers have reported finding Chaga-like growths on birch trees in the northern parts of Georgia, particularly in the Appalachian Mountains, where the climate is cooler and more conducive to its growth.
Reported sightings in Georgia often come from areas with higher elevations, such as the Blue Ridge Mountains, where birch trees are present. Foragers have shared photos and descriptions of dark, charcoal-like growths on birch trees, which resemble Chaga. However, it is crucial to verify these findings, as similar-looking fungi or tree cankers can be mistaken for Chaga. Local mycological clubs and foraging groups in Georgia occasionally organize expeditions to identify and document these growths, contributing to the understanding of Chaga's potential presence in the region.
In addition to anecdotal reports, some online forums and social media groups dedicated to foraging and mushroom identification have featured discussions about Chaga sightings in Georgia. Users often share coordinates or general locations where they have found Chaga-like growths, though these reports should be approached with caution. Proper identification is essential, as misidentification can lead to the harvesting of non-Chaga fungi, which may be ineffective or even harmful if consumed.
For those interested in searching for Chaga in Georgia, it is recommended to focus on areas with mature birch trees, particularly at higher elevations. Winter and early spring are the best times to look for Chaga, as its dark, hard exterior stands out against the lighter bark of birch trees. Always practice sustainable harvesting methods, such as using a sharp knife to remove only a portion of the Chaga while leaving enough to allow regrowth.
Despite the reported sightings, the presence of Chaga in Georgia remains relatively rare compared to its traditional habitats. Climate and environmental factors play a significant role in its growth, and Georgia's generally warmer temperatures may limit its prevalence. Foragers and researchers continue to explore and document these findings, contributing to a growing body of knowledge about Chaga's potential range and adaptability. If you are in Georgia and believe you have found Chaga, consider consulting with local mycologists or experts to confirm your discovery and ensure proper identification.
Do Psychedelic Mushrooms Thrive in Poop? Unveiling the Truth
You may want to see also
Frequently asked questions
Yes, chaga mushrooms (Inonotus obliquus) can grow in Georgia, particularly in the northern regions where birch trees, their primary host, are abundant.
Chaga thrives in cold, humid climates with mature birch trees. Georgia’s mountainous areas, such as the Blue Ridge Mountains, provide suitable conditions for its growth.
Chaga is most likely found in forested areas with birch trees, especially in the northern part of the state, including the Appalachian region.
Harvesting chaga on private land is generally allowed with permission, but regulations may vary on public lands. Always check local laws and obtain necessary permits.
Chaga appears as a black, charcoal-like growth on birch trees, with a rusty-brown interior when cut open. Its distinct appearance makes it relatively easy to identify.